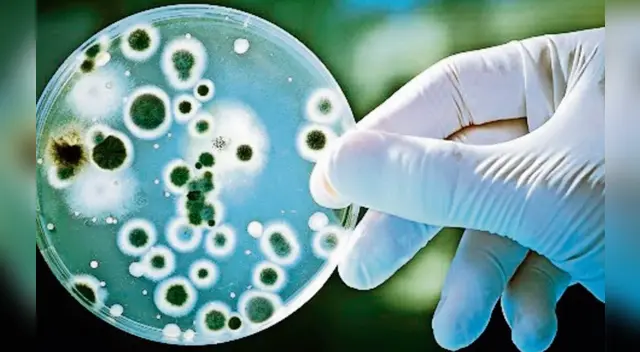
¿Qué es y cuáles son los síntomas de la brucelosis?

Conoce qué es la brucelosis, enfermedad que atacó a más de 3 mil personas en China
El brote de brucelosis en China se produjo por una fuga en una biofarmacéutica afectando a más de 3 mil habitantes del gigante asiático en el 2019. Conoce aquí los detalles de esta 'nueva' enfermedad.
Únete al canal de Whatsapp de El Popular- Confirmado | Exigen el retiro urgente de este pescado de los supermercados por ser un riesgo mortal para la población
- ALARMA en Walmart: ICE se burló y arrestó a padre de familia que huyó de la guerra de Ucrania hacia EE.UU.
China. Un reporte difundido esta semana por la Comisión de Salud de Lanzhou, capital de la provincia china de Gansu, dio a conocer que un total de 3.245 personas fueron contagiadas de brucelosis tras producirse una fuga en la compañía biofarmacéutica de Zhongmu Lanzhou a mediados del año pasado.
Según informó CNN, la autoridad sanitaria local indicó que el brote se produjo entre finales de julio y finales de agosto de 2019 y se tuvo que examinar a 21.847 personas de los 2,9 millones de habitantes de Lanzhou, incluso unas 1.401 personas dieron positivo de brucelosis en la prueba preliminar. Sin embargo, aún no se han reportado muertes producto de esta ‘nueva’ enfermedad.
¿Qué es la brucelosis?
También llamada fiebre de Malta o fiebre mediterránea. Su propagación a humanos se produce ante el contacto de ganados portadores de la bacteria brucella, el cual fue muy común en China en la década de 1980, pero se logró contrarrestar con la aplicación de vacunas.
¿Cuáles son los síntomas de la brucelosis?
Según los Centros para el Control y la Prevención de Enfermedades de Estados Unidos (CDC), la brucelosis podría ocasionar diversos tipos de afecciones como:
- Fiebre.
- Dolores de cabeza.
- Fatiga.
- Dolores musculares.
MIRA TAMBIÉN: Científicos chinos revelan que su candidata a vacuna contra el COVID-19 estaría lista en noviembre
“Aunque estos síntomas pueden ser pasajeros, en ciertas ocasiones algunos pueden devenir en problemas crónicos la artritis o hinchazón en ciertos órganos. De acuerdo al CDC, la transmisión de la brucelosis entre personas es extremadamente rara y la mayoría de los contagios de humanos se generan al comer alimentos contaminados o respirar la bacteria, como parece haber ocurrido en Lanzhou”, informa el medio La Nación.
¿Cómo se produjo el brote de brucelosis?
“La fábrica producía vacunas de brucella para uso animal se utilizaron desinfectantes vencidos. De esta forma, no fueron erradicadas todas las bacterias en el gas residual. A partir de esta negligencia de la farmacéutica permitió que el gas residual contaminado formase aerosoles con la bacteria y se filtre al aire. De esta forma, la bacteria se transportó por el viento hasta el Instituto de Investigación Veterinaria de Lanzhou, donde se registró el primer brote”, indicó el medio citado.
“Según la agencia de noticias estatal chinaXinhua, los contagios comenzaron a cobrar notoriedad en noviembre pasado y se aceleraron rápidamente. Para fines de diciembre, al menos 181 personas en el instituto fueron infectadas con brucelosis", añadió.
"Recién en febrero, la fábrica publicó una disculpa pública donde señaló que había 'castigado severamente' a ocho personas por encontrarlas responsables del brote infeccioso. También informó que cooperará con las autoridades y compensará a los afectados”, concluyó.